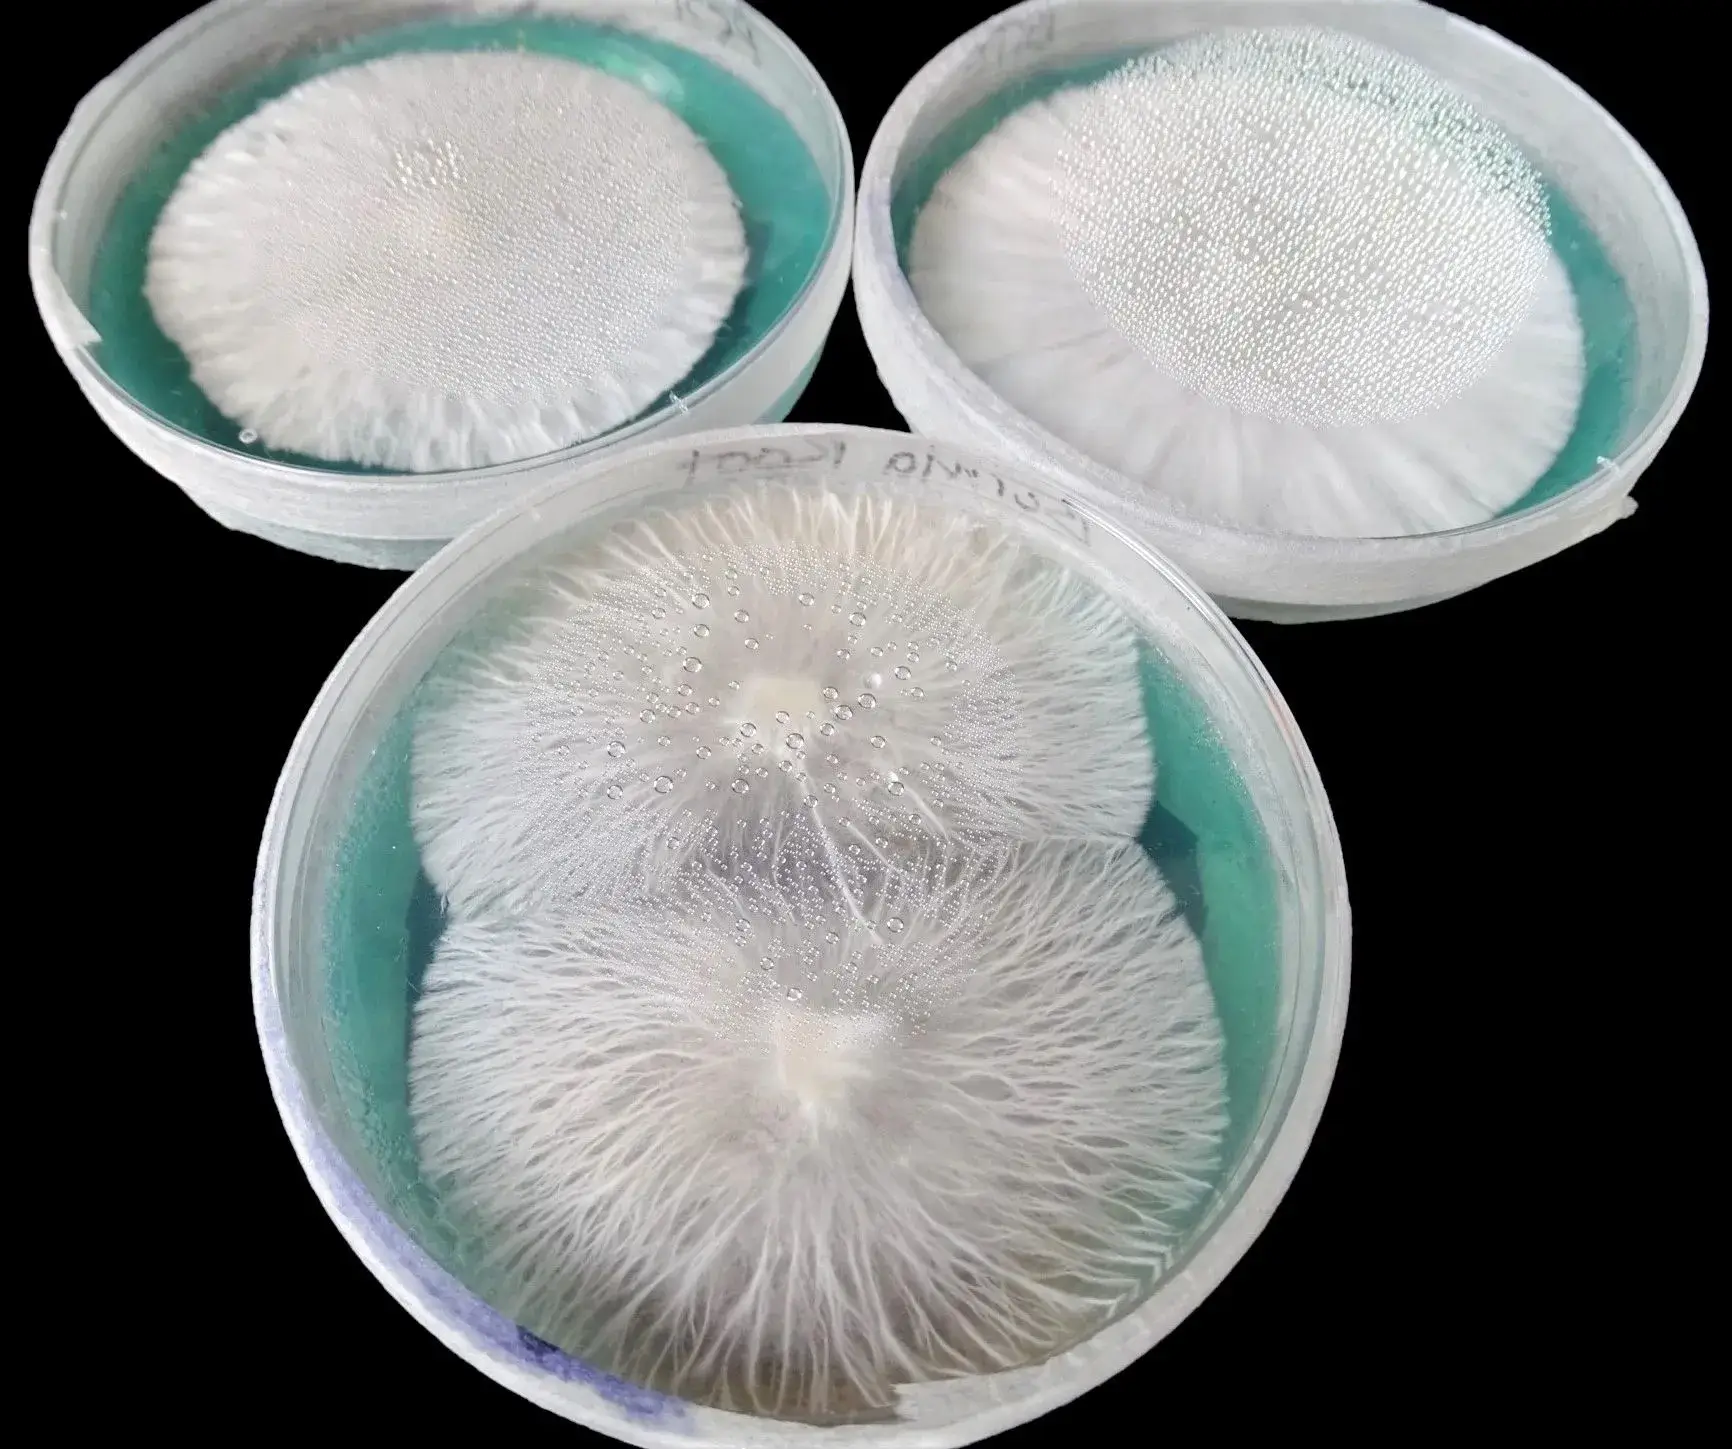
mycelium in agar mycelium in agar

Description
Why Use a Laminar Flow Hood in Mycology?
- Inoculate grain jars and agar plates with minimal contamination risk
- Pour and store agar safely
- Perform tissue cloning or liquid culture prep with confidence
- Work cleaner and faster than with a still air box
- Reduce losses from bacterial or mould infections
Mycology Laminar Flow Hood Features
- Stainless steel work surface: Easy to clean and maintain
- HEPA-filtered airflow: Class 100 air quality with vertical laminar flow
- Infrared remote control: Fan, lighting, and germicidal lamp all controlled wirelessly
- Adjustable fan speed: Extend filter life and maintain performance over time
- Fluorescent and germicidal UV lighting: Built-in for surface and air disinfection
- Quiet operation: Runs below 62dB for a calm workspace
- Built-in safety: Never run lights without the fan, cooling is essential
How to Use the VD-650 Laminar Flow Hood for Mycology
- Place the hood in a clean, dry, draft-free room
- Plug into a 220V AC power outlet
- Use the remote to:
Start fan at low speed (B) for first 18 months
Switch to high speed (A) after extended use
Activate lighting (C) or germicidal UV lamp (D) - Before first use, run with the germicidal lamp on for 4 hours to sterilise internal surfaces
- For ongoing use, run the hood 10 minutes before starting work, then switch to standard lighting
- Never operate the UV lamp with the fan off. Always use the fan when the unit is powered on to prevent overheating.
Technical Specs
- Cleanliness: Class 100 (Fed 209E)
- HEPA Filter Size: 18.8″ x 18″ x 1.5”
- Working Area: 48 × 45 cm (19” x 15” x 18”)
- External Dimensions: 63.5 × 48 × 83 cm (25” x 19” x 33”)
- Max Power: 200W
- Noise Level: ≤ 62dB
- Air Velocity: 0.25–0.45 m/s (adjustable)
- Weight: 50 kg
- Lighting: 10W Fluorescent + 10W UV
- Warranty: 2-Year Manufacturer’s Warranty
Maintenance & Filter Care
- Clean the primary air filter every 3–6 months for maximum airflow
- After ~18 months of use or signs of contamination, switch to high fan speed
- Replace the HEPA filter if air volume drops or if contamination is detected
From Still Air Box to Flow Hood Mycology
If you’re currently using a still air box for mushrooms, this is your logical next step. The VD-650 Laminar Flow Hood offers precision, reliability, and efficiency. You’ll notice a huge difference in spore syringe prep, agar work, and LC transfers.
Order Your Laminar Flow Hood Today
Bring professional-grade sterility to your workspace with the VD-650 Laminar Flow Hood. Take your mycology to the next level and enjoy faster colonisation, cleaner cultures, and better results – every time.